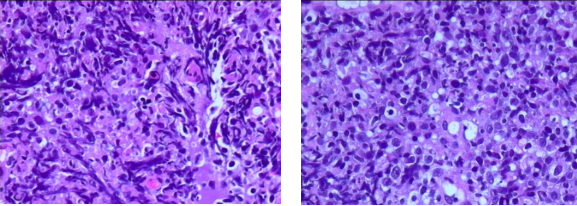
640.png

李文瑜教授团队:CAR-T细胞治疗为高龄DLBCL患者带来持续缓解和长期生存
广东省人民医院淋巴瘤科是华南首家综合医院淋巴瘤单病种专科,是国家重点专科,致力于淋巴瘤临床诊断、规范化和个体化治疗。2018年9月,广东省人民医院淋巴瘤科收治了一例被诊断为弥漫大B细胞淋巴瘤 (DLBCL)的81岁高龄患者。此例患者多线治疗失败后,李文瑜教授团队综合评估并与患者及家属充分沟通,决定为患者行CAR-T细胞治疗,最终患者疗效评估为完全缓解(CR),缓解持续时间近20个月。本期,特邀李文瑜教授分享高龄DLBCL患者的诊疗现状和此例患者的治疗经过和长期随访结果。
(DLBCL)的81岁高龄患者。此例患者多线治疗失败后,李文瑜教授团队综合评估并与患者及家属充分沟通,决定为患者行CAR-T细胞治疗,最终患者疗效评估为完全缓解(CR),缓解持续时间近20个月。本期,特邀李文瑜教授分享高龄DLBCL患者的诊疗现状和此例患者的治疗经过和长期随访结果。
治疗经过
女性,81岁。2004年11月诊断为Burkitt‘s淋巴瘤(侵犯腋窝、腹膜后、腹股沟淋巴结),予:8周期R-CHOP方案、4周期R-ESHAP方案,2005年10月14日予1周期E-CTM方案化疗。疗效评价为CR。后续定期每3~6个月PET/CT复查,未见复发。患者2018年9月底无明显诱因出现下唇部麻木伴刺痛,逐渐加重,2018年11月行腮腺MRI发现右侧上颌窦占位,2018年11月21日行鼻咽镜检查活检,病理提示弥漫性大B细胞淋巴瘤,结合PET/CT为IV期(侵犯全身多发淋巴结、多发骨、右房壁、鼻咽),IPI评分4分,合并双表达。2018年12月20日,给予4周期R-CDOP+西达本胺 ,2周期R+西达本胺,后R单药维持,于2020年11月疾病复发。更换方案为6周期ZR2方案后,ZR维持,于2021年8月14日疾病进展,调整方案为CD20单抗(R)+依托泊苷
,2周期R+西达本胺,后R单药维持,于2020年11月疾病复发。更换方案为6周期ZR2方案后,ZR维持,于2021年8月14日疾病进展,调整方案为CD20单抗(R)+依托泊苷 ,2022年1月12日再次疾病进展,患者入组Loncastuximab Tesirine 临床试验接受治疗,3周期后再次进展。
,2022年1月12日再次疾病进展,患者入组Loncastuximab Tesirine 临床试验接受治疗,3周期后再次进展。
病理学检查
➤提示:(左侧鼻咽)非霍奇金淋巴瘤 ,B细胞性,弥漫大B细胞淋巴瘤,GCB免疫表型亚群
,B细胞性,弥漫大B细胞淋巴瘤,GCB免疫表型亚群
图 1、患者病理学检查结果
➤鼻咽粘膜内见异型的淋巴细胞浸润,瘤细胞中等大,核不规则、染色质较细腻,核仁不明显,弥漫分布,部分细胞挤压变形。
➤免疫组化结果:CD20(+++),CD3(-),CD5(-),CD19(++),EBERs(-),Ki67(90%+),CD30(-),CD23(-),CD10(-),CD21(-),ALK(5A4)(-),Bcl6(60%+),CD138(-),MUM1(-),Bcl2(100%+),Cyclin D1(-),C-myc(70%+)。C-MYC BA FISH(-)
影像学检查

图2、患者PET-CT结果(2022年3月30日)
考虑到患者多线治疗失败,经与患者及家属充分沟通后决定行瑞基奥仑赛CAR-T细胞治疗。
➤2022-4-13采集单个核细胞,采集细胞前后均予激素减瘤治疗
➤2022-4-18考虑患者鼻咽病灶大,予桥接治疗:鼻咽病灶放疗:4Gy×5次,共20Gy
➤2022-5-17清淋化疗(入院时肌酐清除率 28ml/min )→原计划:氟达拉滨 15mg d1-3+环磷酰胺
15mg d1-3+环磷酰胺 150mg d1-3→治疗1日后肌酐清除率下降至22ml/min→环磷酰胺 375mg d2、3(CTX总量 750mg)
150mg d1-3→治疗1日后肌酐清除率下降至22ml/min→环磷酰胺 375mg d2、3(CTX总量 750mg)
➤2022-5-23 回输瑞基奥仑赛注射液 ,CAR-T细胞数量为100×106
,CAR-T细胞数量为100×106
疗效评估
CAR-T回输后疗效评估-完全缓解:CAR-T细胞回输后,获得持续CR。

图3、瑞基奥仑赛CAR-T细胞回输后疗效监测
安全性监测
患者回输后D3起出现ICANS 1级,CRS 1级,予左乙拉西坦 抗癫痫,塞来昔布
抗癫痫,塞来昔布 后症状即得到控制。
后症状即得到控制。

图4、瑞基奥仑赛CAR-T细胞回输后安全性监测
专家访谈
医脉通:能否请您分享下在治疗过程中遇到了哪些困难?您和您的团队是如何处理的呢?
李文瑜 教授
CAR-T细胞治疗对于高龄患者的疗效方面:这是一个2年前的病例,当时CAR-T刚上市,但到底CAR-T对老年人疗效好不好呢?早期的资料显示CAR-T细胞治疗对高龄患者的总体有效率甚至高于年轻患者,高龄患者的细胞因子释放综合征(CRS)与年轻患者相当,神经毒性可能稍高一点[1]。因此,我们才下决心给患者做CAR-T细胞治疗。
单采方面的挑战:当时患者由于高龄,身体比较衰弱、体力状态较差,在有效控制住感染后患者顺利单采。
桥接治疗提高CAR-T细胞治疗的疗效方面:为了提高CAR-T细胞治疗的疗效,在CAR-T细胞回输前给予患者局部分割的大放疗,充分降低肿瘤负荷后输注CAR-T细胞治疗。患者的疗效得到了有效的提高,无进展生存接近20个月。
清淋方案剂量的调整方面:相对来说,由于老年人年老体弱,脏器功能受到很大挑战。该患者的肾功能达不到肌酐清除率30ml/min。患者无法耐受常规剂量的氟达拉滨和环磷酰胺清淋化疗方案。根据药代动力学,采用足量的环磷酰胺清淋方案成功清淋,为后续CAR-T细胞在体内扩增创造了较好的免疫微环境。
CAR-T治疗后免疫力下降方面:当时遇到了新冠大流行,患者在回输后感染了新冠,免疫力下降,及时给予新冠特效药物同时输注免疫球蛋白,该患者成功经受住了新冠病毒的打击。患者获得了有效的生存,而且生活质量非常好。最终,通过患者、家属与医生三方力量的配合,目前患者持续缓解时间接近20个月。
医脉通:能否请问您和您的团队是基于何种考虑,最终选择使用CAR-T对患者治疗呢?目前疗效如何?
李文瑜 教授
依据NCCN指南和CSCO指南的推荐,CAR-T细胞治疗对三线及以上复发难治的DLBCL是一个较优的选择[2-3]。国内多款CAR-T细胞产品已经批准应用于复发难治的DLBCL。从瑞基奥仑赛注射液的临床数据来看,商业化CAR-T细胞剂量队列中,2年的PFS率接近50%,2年的OS率超过80%;在安全性方面,患者的CRS和ICANS很低,3-4级的毒副作用没有超过5%[4-5]。当时我们科室参加了瑞基奥仑赛的注册临床试验,考虑到瑞基奥仑赛临床数据疗效显著且副作用较低,所以是我们为该高龄、体弱患者的用药首选。到目前为止,该患者已近20个月的完全缓解,也证明了瑞基奥仑赛的CAR-T细胞治疗疗效显著,同时副作用低,因此我们也受到非常大的鼓舞。
医脉通:能否请您分享一下高龄患者应用CAR-T细胞治疗的经验?
李文瑜 教授
随着CAR-T在中国获批上市,更多的患者有机会应用CAR-T细胞治疗,其中就包括老年体弱的患者。CAR-T细胞治疗为患者带来了潜在治愈的可能可以使患者获得长期生存。在刚刚结束的2023 ASH会议上,多篇壁报展示和继续教育均显示,CAR-T细胞治疗同样适用于高龄患者,所以CAR-T细胞治疗的安全性和有效性在高龄患者的应用可能是一种优异的治疗选择[6-7]。真实世界中,我们科室接收了多例80岁以上的患者,在应用CAR-T细胞治疗后均达到了完全缓解,而且患者获得了长期生存。因此,我们对瑞基奥仑赛在高龄患者中的疗效和良好安全性还是非常有信心。此外,瑞基奥仑赛的共刺激域是4-1BB,CAR-T细胞在患者体内存活的时间长,CRS和神经毒性较低。因此,我们推荐瑞基奥仑赛可以作为高龄患者接受CAR-T细胞治疗的选择。
总结
高龄并非影响CAR-T细胞治疗的预后因素,研究表明高龄患者和年轻患者的疗效相当,安全可控[6-7]。本病例中瑞基奥仑赛为81岁的高龄DLBCL患者带来了持续缓解和长期生存,目前持续缓解时间已近20个月,仅发生了1级CRS和1级ICANS,因此高龄的DLBCL患者亦可以从CAR-T细胞治疗中获益。

李文瑜 教授
主任医师、硕士生导师、医学博士
广东省人民医院肿瘤医院 淋巴瘤科 行政主任
广东省基层医药学会淋巴瘤专业委员会主任委员
广东省女医师协会淋巴瘤专业委员会主任委员
广东省女医师协会血液学专业委员会副主任委员
广东省医学会肿瘤内科分会副主任委员
广州市血液肿瘤专业委员会副主任委员
广州市抗癌协会淋巴瘤专业委员会副主任委员
CACA青年委员会委员
美国血液协会会员
研究方向:淋巴瘤
从事肿瘤临床工作20年,长期从事淋巴瘤的诊断治疗,具有丰富的淋巴瘤诊治经验。
开展恶性淋巴瘤发病机制、临床诊断、临床治疗技术等的研究。积极申请科研课题,已经申请到广东省人民医院科研基金及广东省科技计划项目、广东省自然基金及国家自然基金。发表论文20余篇。

